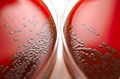

Экспертное заключение об эффективности и безопасности препарата циклоферон таб. п/о в лечении и профилактике гриппа и других ОРВИ. Директор ФГБУ «НИИ гриппа» Минздрава России, д. б. н., проф., академик РАМН О. И. Киселев.
Экспертное заключение об эффективности и безопасности препарата циклоферон таб. п/о в лечении и профилактике гриппа и других ОРВИ. Директор ФГБУ «НИИ гриппа» Минздрава России, д. б. н., проф., академик РАМН О. И. Киселев.
Хорошо ли вы осведомлены о том, как лечиться от болезней, особенно в преддверии сезона простуд? Для этого надо разобраться в нескольких базовых понятиях, а уже после выбрать подходящий лекарственный препарат.
 Бешенство – это смертельное инфекционное заболевание, протекающее с поражением нервной системы. Чаще всего заражение происходит в результате укуса инфицированной собакой или кошкой. Лечение бешенства не разработано. Однако существуют эффективные методы профилактики этого заболевания, которые заключаются в вакцинации пострадавшего человека и введении антирабического иммуноглобулина или сыворотки.
Бешенство – это смертельное инфекционное заболевание, протекающее с поражением нервной системы. Чаще всего заражение происходит в результате укуса инфицированной собакой или кошкой. Лечение бешенства не разработано. Однако существуют эффективные методы профилактики этого заболевания, которые заключаются в вакцинации пострадавшего человека и введении антирабического иммуноглобулина или сыворотки.
 Болезнь Лайма – инфекционное заболевание, вызываемое спирохетами Borrelia burgdorferi и передающееся клещами. Характеризуется наклонностью к хроническому и рецидивирующему течению и преимущественным поражением кожи, нервной системы, опорно-двигательного аппарата и сердца.
Болезнь Лайма – инфекционное заболевание, вызываемое спирохетами Borrelia burgdorferi и передающееся клещами. Характеризуется наклонностью к хроническому и рецидивирующему течению и преимущественным поражением кожи, нервной системы, опорно-двигательного аппарата и сердца.
 Бруцеллез – это инфекционное заболевание, которое может поражать лимфоузлы, опорно-двигательный аппарат, нервную систему, внутренние органы.
Бруцеллез – это инфекционное заболевание, которое может поражать лимфоузлы, опорно-двигательный аппарат, нервную систему, внутренние органы.
 Тиф – это бактериальная инфекция, которая поражает сначала кишечник, затем распространяется на печень, селезенку и желчный пузырь. Это высоко заразное заболевание, передающееся через воду и пищу, содержащие возбудителя. Даже выздоровевший после тифа человек может в течение многих лет оставаться носителем бактерий, вызывающих тиф.
Тиф – это бактериальная инфекция, которая поражает сначала кишечник, затем распространяется на печень, селезенку и желчный пузырь. Это высоко заразное заболевание, передающееся через воду и пищу, содержащие возбудителя. Даже выздоровевший после тифа человек может в течение многих лет оставаться носителем бактерий, вызывающих тиф.
 Если у вашего ребенка ВИЧ-инфекция, не отчаивайтесь. Помните: достижения современной медицины позволяют ВИЧ-положительным детям жить полной, активной интересной жизнью. Развитие ВИЧ-инфекции у детей проходит иначе, чем у взрослых. У малышей, инфицированных ВИЧ во время беременности или родов, развитие ВИЧ-инфекции может проходить быстрее, и без лечения достаточно велик риск того, что ребенок серьезно заболеет уже в первые годы жизни. ВИЧ-положительные дети медленнее развиваются и половое созревание у них начинается позже, однако в целом ВИЧ-положительные дети развиваются нормально.
Если у вашего ребенка ВИЧ-инфекция, не отчаивайтесь. Помните: достижения современной медицины позволяют ВИЧ-положительным детям жить полной, активной интересной жизнью. Развитие ВИЧ-инфекции у детей проходит иначе, чем у взрослых. У малышей, инфицированных ВИЧ во время беременности или родов, развитие ВИЧ-инфекции может проходить быстрее, и без лечения достаточно велик риск того, что ребенок серьезно заболеет уже в первые годы жизни. ВИЧ-положительные дети медленнее развиваются и половое созревание у них начинается позже, однако в целом ВИЧ-положительные дети развиваются нормально.
 СПИД – одна из важнейших проблем, возникших перед человечеством в конце XX века. В настоящее время в мире официально зарегистрировано более 40 миллионов ВИЧ-инфицированных. В России общее количеств зарегистрированных людей с ВИЧ приближается к 500 000. СПИД относится к числу пяти главных заболеваний, уносящих наибольшее число жизней на планете. ВИЧ влияет не только на здоровье отдельного человека, но и на государство и общество в целом. Проблемы, которые возникают в обществе из-за распространения ВИЧ, касаются так или иначе всех нас.
СПИД – одна из важнейших проблем, возникших перед человечеством в конце XX века. В настоящее время в мире официально зарегистрировано более 40 миллионов ВИЧ-инфицированных. В России общее количеств зарегистрированных людей с ВИЧ приближается к 500 000. СПИД относится к числу пяти главных заболеваний, уносящих наибольшее число жизней на планете. ВИЧ влияет не только на здоровье отдельного человека, но и на государство и общество в целом. Проблемы, которые возникают в обществе из-за распространения ВИЧ, касаются так или иначе всех нас.
.jpg) Всемирный день борьбы со СПИДом, который, начиная с 1988 года, отмечается 1 декабря – одна из немногих памятных дат, выбранная не по принципу "кто-то родился, умер" или "что-то случилось в этот день". В конце 80-х стало понятно, что ВИЧ/СПИД – серьезнейшая проблема века и нужно привлечь внимание общества к этой проблеме, а дата должна быть легко запоминающейся, как, например, первый день зимы.
Всемирный день борьбы со СПИДом, который, начиная с 1988 года, отмечается 1 декабря – одна из немногих памятных дат, выбранная не по принципу "кто-то родился, умер" или "что-то случилось в этот день". В конце 80-х стало понятно, что ВИЧ/СПИД – серьезнейшая проблема века и нужно привлечь внимание общества к этой проблеме, а дата должна быть легко запоминающейся, как, например, первый день зимы.
 Гепатит А – вирусная инфекция, одна из наиболее распространенных причин воспаления печени во всем мире. Заражение происходит в основном через загрязненные продукты питания и воду. Играют роль непосредственный контакт с больным, а также пользование одной посудой и общим туалетом. Вирус может сохраняться на руках человека несколько часов, а на пище при комнатной температуре еще дольше.
Гепатит А – вирусная инфекция, одна из наиболее распространенных причин воспаления печени во всем мире. Заражение происходит в основном через загрязненные продукты питания и воду. Играют роль непосредственный контакт с больным, а также пользование одной посудой и общим туалетом. Вирус может сохраняться на руках человека несколько часов, а на пище при комнатной температуре еще дольше.
 Гепатит В – это системное вирусное заболевание, которое характеризуется поражением печени и различными внепеченочными проявлениями. Гепатит В может протекать в виде острой или хронической инфекции. Острый гепатит В в 85-90% случаев завершается выздоровлением. У 10% заболевших инфекция принимает характер хронической.
Гепатит В – это системное вирусное заболевание, которое характеризуется поражением печени и различными внепеченочными проявлениями. Гепатит В может протекать в виде острой или хронической инфекции. Острый гепатит В в 85-90% случаев завершается выздоровлением. У 10% заболевших инфекция принимает характер хронической.
 Гепатит C – это инфекционное заболевание печени, вызываемое вирусом гепатита С. Чтобы заражение вирусом гепатита C осуществилось, необходимо, чтобы материал, содержащий вирус (кровь инфицированного человека) попал в кровяное русло другого человека. Более чем 2% населения мира заражено этим вирусом и с каждым годом заболеваемость гепатитом С растет.
Гепатит C – это инфекционное заболевание печени, вызываемое вирусом гепатита С. Чтобы заражение вирусом гепатита C осуществилось, необходимо, чтобы материал, содержащий вирус (кровь инфицированного человека) попал в кровяное русло другого человека. Более чем 2% населения мира заражено этим вирусом и с каждым годом заболеваемость гепатитом С растет.
 Герпесом называют инфекцию, которую вызывает вирус простого герпеса типов 1 и 2 (Herpesvirus hominis). Источником заражения служат больные со свежими герпетическими высыпаниями и носители, выделяющие вирус в окружающую среду. Особенностью вируса герпеса является то, что он способен проникать в нервные волокна и ганглии и сохранятся в них длительное время в латентном (спящем) состоянии. Этим объясняется рецидивирующее течение заболевания с периодами обострения и ремиссии.
Герпесом называют инфекцию, которую вызывает вирус простого герпеса типов 1 и 2 (Herpesvirus hominis). Источником заражения служат больные со свежими герпетическими высыпаниями и носители, выделяющие вирус в окружающую среду. Особенностью вируса герпеса является то, что он способен проникать в нервные волокна и ганглии и сохранятся в них длительное время в латентном (спящем) состоянии. Этим объясняется рецидивирующее течение заболевания с периодами обострения и ремиссии.
 Гонорея является одной из самых распространенных венерических инфекций, сопровождающейся болью при мочеиспускании и желтовато-белыми выделениями.
Гонорея является одной из самых распространенных венерических инфекций, сопровождающейся болью при мочеиспускании и желтовато-белыми выделениями.
 Грипп – это вирусная инфекция, поражающая нос, горло и иногда легкие. Как правило, для практически здоровых людей грипп неопасен.
Грипп – это вирусная инфекция, поражающая нос, горло и иногда легкие. Как правило, для практически здоровых людей грипп неопасен.
 Актуальные советы: как узнать, что вы заболели? Что нужно делать, если вы заболели? Какие существуют тревожные симптомы? Какие есть лекарства и в каких случаях их нужно принимать?
Актуальные советы: как узнать, что вы заболели? Что нужно делать, если вы заболели? Какие существуют тревожные симптомы? Какие есть лекарства и в каких случаях их нужно принимать?
 Течение ВИЧ-инфекции характеризуется длительным отсутствием существенных специфичных симптомов болезни. Острая фаза начинается через 3-6 недель после заражения, продолжается в течение 1-2 недель и в силу не специфичности симптомов, как правило, принимается за обычную ОРВИ. В этот период больного может беспокоить лихорадка, увеличение лимфатических узлов, головная боль, боли в суставах. Острую фазу заболевания сменяет длительный бессимптомный период, продолжительностью до 10 лет и более. Клинические признаки вновь появляются только при интенсивном размножении вируса и значимом поражении клеток иммунной системы, при котором происходит переход заболевания в развернутую стадию. Клинические проявления заболевания становятся значимыми лишь на поздних стадиях заболевания. Поэтому в диагностике ВИЧ-инфекции первостепенную роль играют лабораторные методы исследования.
Течение ВИЧ-инфекции характеризуется длительным отсутствием существенных специфичных симптомов болезни. Острая фаза начинается через 3-6 недель после заражения, продолжается в течение 1-2 недель и в силу не специфичности симптомов, как правило, принимается за обычную ОРВИ. В этот период больного может беспокоить лихорадка, увеличение лимфатических узлов, головная боль, боли в суставах. Острую фазу заболевания сменяет длительный бессимптомный период, продолжительностью до 10 лет и более. Клинические признаки вновь появляются только при интенсивном размножении вируса и значимом поражении клеток иммунной системы, при котором происходит переход заболевания в развернутую стадию. Клинические проявления заболевания становятся значимыми лишь на поздних стадиях заболевания. Поэтому в диагностике ВИЧ-инфекции первостепенную роль играют лабораторные методы исследования.
 Желтая лихорадка – это острое вирусное заболевание, которое передается комарами и характеризуется тяжелыми изменениями со стороны крови, высокой температурой тела, поражением печени и почек.
Желтая лихорадка – это острое вирусное заболевание, которое передается комарами и характеризуется тяжелыми изменениями со стороны крови, высокой температурой тела, поражением печени и почек.
 Эти инфекции передаются от человека к человеку при половом контакте. К наиболее распространенным ЗППП можно отнести генитальный герпес, хламидиоз, вирус папилломы человека (ВПЧ), остроконечные кондиломы (генитальные бородавки), мягкий шанкр и сифилис (твердый шанкр), уретриты и вагиниты гонококковой (гонорея) и негонококковой (неспецифические) природы.
Эти инфекции передаются от человека к человеку при половом контакте. К наиболее распространенным ЗППП можно отнести генитальный герпес, хламидиоз, вирус папилломы человека (ВПЧ), остроконечные кондиломы (генитальные бородавки), мягкий шанкр и сифилис (твердый шанкр), уретриты и вагиниты гонококковой (гонорея) и негонококковой (неспецифические) природы.
.jpg) Инфекционный мононуклеоз – это заболевание, возбудителем которого является вирус Эпштейна-Барр. Оно характеризуется лихорадкой, увеличением лимфатических узлов, воспалением небных миндалин и определенными изменениями в клетках крови.
Инфекционный мононуклеоз – это заболевание, возбудителем которого является вирус Эпштейна-Барр. Оно характеризуется лихорадкой, увеличением лимфатических узлов, воспалением небных миндалин и определенными изменениями в клетках крови.
 Кандидоз – это заболевание, вызываемое дрожжеподобными грибами рода Candida, в основном Candida albiсans.
Кандидоз – это заболевание, вызываемое дрожжеподобными грибами рода Candida, в основном Candida albiсans.
 Клещевой энцефалит – это вирусное, природно-очаговое (характерное только для определенных территорий) заболевание с преимущественным поражением центральной нервной системы. Разносчиками инфекции являются иксодовые клещи, вирус передается при укусе больного клеща. Инфекция также поражает и животных – грызунов, домашний скот, обезьян, некоторых птиц.
Клещевой энцефалит – это вирусное, природно-очаговое (характерное только для определенных территорий) заболевание с преимущественным поражением центральной нервной системы. Разносчиками инфекции являются иксодовые клещи, вирус передается при укусе больного клеща. Инфекция также поражает и животных – грызунов, домашний скот, обезьян, некоторых птиц.
 Краснуха является вирусной инфекцией, при которой на теле появляется сыпь, сходная с сыпью при обычной кори. Но в отличие от кори, которая представляет собой серьёзное, зачастую угрожающее жизни заболевание, краснуха менее опасна.
Краснуха является вирусной инфекцией, при которой на теле появляется сыпь, сходная с сыпью при обычной кори. Но в отличие от кори, которая представляет собой серьёзное, зачастую угрожающее жизни заболевание, краснуха менее опасна.
.jpg) Лепра, так же именуемая проказой, представляет собой заболевание, которое поражает кожу и периферические нервы. В тяжелых случаях затрагиваются и внутренние органы.
Лепра, так же именуемая проказой, представляет собой заболевание, которое поражает кожу и периферические нервы. В тяжелых случаях затрагиваются и внутренние органы.
 До настоящего времени не разработано лечения ВИЧ-инфекции, которое могло бы полностью устранить вирус из организма. Однако современный тактика терапии способна замедлить прогрессирование инфекции и её переход в стадию СПИД, позволяя ВИЧ-инфицированному человеку на протяжении десятилетий жить полноценной жизнью. Терапия требует тесного сотрудничества пациента и врача, четкого выполнения всех рекомендаций и аккуратного своевременного приема лекарств.
До настоящего времени не разработано лечения ВИЧ-инфекции, которое могло бы полностью устранить вирус из организма. Однако современный тактика терапии способна замедлить прогрессирование инфекции и её переход в стадию СПИД, позволяя ВИЧ-инфицированному человеку на протяжении десятилетий жить полноценной жизнью. Терапия требует тесного сотрудничества пациента и врача, четкого выполнения всех рекомендаций и аккуратного своевременного приема лекарств.
 Лихорадка Денге, также известная как тропическая лихорадка, представляет собой острую вирусную инфекцию, переносимую москитом Aedes aegypti, который размножается в стоячих водоёмах и активен в течение светлого времени суток. Одним из симптомов является сильная мышечная боль.
Лихорадка Денге, также известная как тропическая лихорадка, представляет собой острую вирусную инфекцию, переносимую москитом Aedes aegypti, который размножается в стоячих водоёмах и активен в течение светлого времени суток. Одним из симптомов является сильная мышечная боль.
 Малярия представляет собой серьёзное инфекционное заболевание, в основном передающееся человеку комарами вида Anopheles. Кроме того, это заболевание может передаваться от матери к плоду, при переливании заражённой крови и через контакт с кровью инфицированного человека (например, при повторном использовании шприцов наркоманами).
Малярия представляет собой серьёзное инфекционное заболевание, в основном передающееся человеку комарами вида Anopheles. Кроме того, это заболевание может передаваться от матери к плоду, при переливании заражённой крови и через контакт с кровью инфицированного человека (например, при повторном использовании шприцов наркоманами).
 Менингит – это воспаление мягких оболочек вокруг головного и спинного мозга, которое может быть вызвано бактериями и вирусами. Бактериальный менингит и менингококковая септицемия являются очень серьезными заболеваниями и нуждаются в срочном лечении антибиотиками.
Менингит – это воспаление мягких оболочек вокруг головного и спинного мозга, которое может быть вызвано бактериями и вирусами. Бактериальный менингит и менингококковая септицемия являются очень серьезными заболеваниями и нуждаются в срочном лечении антибиотиками.
 Описторхоз – это паразитарное заболевание, при котором плоский червь рода Opisthorchis (описторх) заселяет желчный пузырь и желчевыводящие пути, печень, протоки поджелудочной железы
Описторхоз – это паразитарное заболевание, при котором плоский червь рода Opisthorchis (описторх) заселяет желчный пузырь и желчевыводящие пути, печень, протоки поджелудочной железы
 Опоясывающий лишай (син. – опоясывающий герпес) – заболевание, представляющее собой реактивацию дремлющей вирусной инфекции, который поражает нервную систему и кожу. Возбудитель – вирус ветряной оспы (вирус герпеса 3 типа). При поражении двигательных ветвей нервов могут возникнуть параличи, поражение глаза в различной степени, задержка мочеиспускания, запоры или понос. Со стороны внутренних органов могут быть осложнения в виде воспаления легких, гепатита, поражения двенадцатиперстной кишки, мочевого пузыря и др.
Опоясывающий лишай (син. – опоясывающий герпес) – заболевание, представляющее собой реактивацию дремлющей вирусной инфекции, который поражает нервную систему и кожу. Возбудитель – вирус ветряной оспы (вирус герпеса 3 типа). При поражении двигательных ветвей нервов могут возникнуть параличи, поражение глаза в различной степени, задержка мочеиспускания, запоры или понос. Со стороны внутренних органов могут быть осложнения в виде воспаления легких, гепатита, поражения двенадцатиперстной кишки, мочевого пузыря и др.
Автор: врач-педиатр, врач семейной медицины, член Международной Ассоциации педиатров, член Европейской ассоциации семейных врачей, кандидат медицинских наук Журбий Оксана Евгеньевна
 Остеомиелит – это воспаление, и хотя формально обычно указывается костный мозг, фактически процесс затрагивает все структуры кости, включая надкостницу, губчатое и компактное вещества, а также прилегающие к пораженным участкам мягкие ткани.
Остеомиелит – это воспаление, и хотя формально обычно указывается костный мозг, фактически процесс затрагивает все структуры кости, включая надкостницу, губчатое и компактное вещества, а также прилегающие к пораженным участкам мягкие ткани.
 Панариций – это острое гнойное воспаление тканей пальцев рук или ног, редко могут затрагиваться ладони.
Панариций – это острое гнойное воспаление тканей пальцев рук или ног, редко могут затрагиваться ладони.
На сегодняшний день вирусу присвоен статус пандемии, что отражает степень его распространения и массовый повальный характер, поражающий значительную часть населения. И, хотя вирус Зика не циркулирует на территории России, отправляясь в эндемичные страны, необходимо знать о последствиях этой болезни.
 Пищевое отравление может возникнуть, если человек съедает продукты, зараженнные бактериями, вирусами, мелкими животными или растениями (например, планктоном), грибами, паразитами или токсинами. Однако далеко не во всех случаях после попадания в организм человека таких продуктов разовьется заболевание. Одни люди более устойчивы к ним, другие легче заражаются и болеют тяжелее.
Пищевое отравление может возникнуть, если человек съедает продукты, зараженнные бактериями, вирусами, мелкими животными или растениями (например, планктоном), грибами, паразитами или токсинами. Однако далеко не во всех случаях после попадания в организм человека таких продуктов разовьется заболевание. Одни люди более устойчивы к ним, другие легче заражаются и болеют тяжелее.
 Менингит – это воспаление мягких оболочек, окружающих головной и спинной мозг, которое может быть вызвано разными микроорганизмами. Наиболее тяжело протекает менингит, вызванный бактериями Neisseria meningitidis – менингококковой инфекцией.
Менингит – это воспаление мягких оболочек, окружающих головной и спинной мозг, которое может быть вызвано разными микроорганизмами. Наиболее тяжело протекает менингит, вызванный бактериями Neisseria meningitidis – менингококковой инфекцией.
 Бешенство – является неизлечимым инфекционным заболеванием. Своевременная вакцинация является единственным способом профилактики после укуса инфицированного животного. Следует помнить, что oт момента инфициования до появления симптомов заболевания проходит некоторое время, и на момент контакта укусившее животное может выглядеть абсолютно здоровым. Не опасаться заражения можно только в том случае, когда Вы точно уверены, что животное было своевременно привито (например, если речь идет о Вашей собаке или собаке соседей по даче).
Бешенство – является неизлечимым инфекционным заболеванием. Своевременная вакцинация является единственным способом профилактики после укуса инфицированного животного. Следует помнить, что oт момента инфициования до появления симптомов заболевания проходит некоторое время, и на момент контакта укусившее животное может выглядеть абсолютно здоровым. Не опасаться заражения можно только в том случае, когда Вы точно уверены, что животное было своевременно привито (например, если речь идет о Вашей собаке или собаке соседей по даче).
 В этой статье мы приведем ряд наиболее важных прививок для путешественников. Необходимость каждой вакцинации следует обсуждать с лечащим врачом или врачом прививочного центра. Помните, что перед любой прививкой Вас должен осмотреть врач для исключения противопоказаний.
В этой статье мы приведем ряд наиболее важных прививок для путешественников. Необходимость каждой вакцинации следует обсуждать с лечащим врачом или врачом прививочного центра. Помните, что перед любой прививкой Вас должен осмотреть врач для исключения противопоказаний.
 Профилактика ВИЧ-инфекции должна быть направлена на снижение индивидуального риска заражения. К счастью пути инфицирования вирусом досконально изучены. Соблюдение ряда профилактических мер позволяет в большинстве случаев предотвратить инфицирование.
Профилактика ВИЧ-инфекции должна быть направлена на снижение индивидуального риска заражения. К счастью пути инфицирования вирусом досконально изучены. Соблюдение ряда профилактических мер позволяет в большинстве случаев предотвратить инфицирование.
 Для вирусов гриппа характерна высокая видоспецифичность. Это означает, что вирусы, инфицирующие отдельные виды (людей, определенные виды птиц, свиней, лошадей и тюленей) остаются верны этим видам и только в редких случаях выходят за их пределы и инфицируют другие виды. Однако проблема заключается в том, что если вирус гриппа животных все-таки преодолевает видовой барьер и инфицирует человека, организм оказывается совершенно незащищенным и неприспособленным к такому заболеванию. По сути, это новый вирус, который неизвестен нашей иммунной системе, а значит, очень опасен.
Для вирусов гриппа характерна высокая видоспецифичность. Это означает, что вирусы, инфицирующие отдельные виды (людей, определенные виды птиц, свиней, лошадей и тюленей) остаются верны этим видам и только в редких случаях выходят за их пределы и инфицируют другие виды. Однако проблема заключается в том, что если вирус гриппа животных все-таки преодолевает видовой барьер и инфицирует человека, организм оказывается совершенно незащищенным и неприспособленным к такому заболеванию. По сути, это новый вирус, который неизвестен нашей иммунной системе, а значит, очень опасен.
Рожа или рожистое воспаление – серьезное инфекционное заболевание, внешними проявлениями которого является прогрессирующие поражение (воспаление) кожного покрова. Причина заболевания – проникновение стрептококка через поврежденную царапинами, ссадинами, потертостями, опрелостью и т.п. кожу. При отсутствии лечения больному угрожают осложнения со стороны почек и сердечно-сосудистой системы (ревматизм, нефрит, миокардит).
Рожа или рожистое воспаление – серьезное инфекционное заболевание, внешними проявлениями которого является прогрессирующие поражение (воспаление) кожного покрова. Причина заболевания – проникновение стрептококка через поврежденную царапинами, ссадинами, потертостями, опрелостью и т.п. кожу. При отсутствии лечения больному угрожают осложнения со стороны почек и сердечно-сосудистой системы (ревматизм, нефрит, миокардит).
 Свиной грипп или грипп A (H1N1) – это респираторное заболевание, вызываемое вирусом гриппа А, чаще всего подтипом H1N1.
Свиной грипп или грипп A (H1N1) – это респираторное заболевание, вызываемое вирусом гриппа А, чаще всего подтипом H1N1.
 Вот простые меры, которые помогут вам защититься от вируса гриппа A (H1N1), или свиного гриппа.
Вот простые меры, которые помогут вам защититься от вируса гриппа A (H1N1), или свиного гриппа.
 Вы можете защититься от инфицирования, если будете избегать тесных контактов с людьми с гриппоподобными симптомами, соблюдать правила общей гигиены. При ношении маски также важно соблюдать определенные правила. При появлении симптомов заболевания следует обращаться к врачу, а не заниматься самолечением.
Вы можете защититься от инфицирования, если будете избегать тесных контактов с людьми с гриппоподобными симптомами, соблюдать правила общей гигиены. При ношении маски также важно соблюдать определенные правила. При появлении симптомов заболевания следует обращаться к врачу, а не заниматься самолечением.
 Сибирская язва – это острое инфекционное заболевание, относящееся к зоонозам, то есть заражение происходит через животных. Сибирская язва может протекать в виде легочной или кишечной форм, но абсолютное большинство случаев относится к кожной форме.
Сибирская язва – это острое инфекционное заболевание, относящееся к зоонозам, то есть заражение происходит через животных. Сибирская язва может протекать в виде легочной или кишечной форм, но абсолютное большинство случаев относится к кожной форме.
 Что следует предпринять родителям, чтобы уберечь своих детей и других членов семьи от гриппа в этом учебном году.
Что следует предпринять родителям, чтобы уберечь своих детей и других членов семьи от гриппа в этом учебном году.
 Синдром приобретенного иммунодефицита – заболевание, которое поражает систему защиты организма от инфекций. Даже самая незначительная инфекция, от которой здоровый организм может легко избавиться, у больных СПИД может привести к серьезным последствиям.
Синдром приобретенного иммунодефицита – заболевание, которое поражает систему защиты организма от инфекций. Даже самая незначительная инфекция, от которой здоровый организм может легко избавиться, у больных СПИД может привести к серьезным последствиям.
 Столбняк – это инфекционное заболевание, которое поражает нервную систему. Столбняк попадает в организм через рану или порез. Бактерии могут попасть в организм даже через небольшие царапины и ранки, но особенно опасны глубокие раны от гвоздей или лезвий. Бактерии столбняка есть везде: их часто находят в почве, пыли и навозе. Столбняк приводит к спазму жевательных и дыхательных мышц.
Столбняк – это инфекционное заболевание, которое поражает нервную систему. Столбняк попадает в организм через рану или порез. Бактерии могут попасть в организм даже через небольшие царапины и ранки, но особенно опасны глубокие раны от гвоздей или лезвий. Бактерии столбняка есть везде: их часто находят в почве, пыли и навозе. Столбняк приводит к спазму жевательных и дыхательных мышц.
 Токсоплазмоз – это широко распространенное паразитарное заболевание человека и животных, которое вызывается простейшими микроорганизмами. Заражение человека происходит от домашних животных и грызунов. Наибольшую опасность токсоплазмоз представляет для беременных, так как в результате заражения беременной может произойти гибель плода.
Токсоплазмоз – это широко распространенное паразитарное заболевание человека и животных, которое вызывается простейшими микроорганизмами. Заражение человека происходит от домашних животных и грызунов. Наибольшую опасность токсоплазмоз представляет для беременных, так как в результате заражения беременной может произойти гибель плода.
 Трихомониаз представляет собой инфекционное заболевание, возбудителем которого является трихомонада.
Трихомониаз представляет собой инфекционное заболевание, возбудителем которого является трихомонада.
 Под уреаплазмозом подразумевают наличие воспалительного процесса в мочеполовой системе, при котором, в ходе лабораторных исследований, выявляется уреаплазма и не обнаружен другой возбудитель. Чаще всего заражение уреаплазмозом происходит половым путем при контакте с больным, либо носителем возбудителя заболевания. Во время родов также существует вероятность заражения ребенка, при прохождении им родовых путей: микробы могут попадать в половые пути ребёнка и сохраняться там всю жизнь, находясь в неактивном состоянии. Уреаплазмоз проявляется не сразу, не беспокоя человека долгое время. Отсутствие симптомов заболевания в некоторых случаях может привести к переходу уреаплазмоза в хроническую стадию и довольно серьезным последствиям для здоровья человека.
Под уреаплазмозом подразумевают наличие воспалительного процесса в мочеполовой системе, при котором, в ходе лабораторных исследований, выявляется уреаплазма и не обнаружен другой возбудитель. Чаще всего заражение уреаплазмозом происходит половым путем при контакте с больным, либо носителем возбудителя заболевания. Во время родов также существует вероятность заражения ребенка, при прохождении им родовых путей: микробы могут попадать в половые пути ребёнка и сохраняться там всю жизнь, находясь в неактивном состоянии. Уреаплазмоз проявляется не сразу, не беспокоя человека долгое время. Отсутствие симптомов заболевания в некоторых случаях может привести к переходу уреаплазмоза в хроническую стадию и довольно серьезным последствиям для здоровья человека.
 Холера – это заболевание пищеварительной системы, вызываемой бактерией Vibrio cholerae. В развитых странах (в Европе, США, Австралии) холера встречается чрезвычайно редко, однако в других регионах мира (многие страны Азии, Африки, Южной Америки) она все еще довольно распространена
Холера – это заболевание пищеварительной системы, вызываемой бактерией Vibrio cholerae. В развитых странах (в Европе, США, Австралии) холера встречается чрезвычайно редко, однако в других регионах мира (многие страны Азии, Африки, Южной Америки) она все еще довольно распространена
 Хронический гепатит – это заболевание, для которого характерны воспаление и некроз печеночной паренхимы, сохраняющиеся на протяжении шести и более месяцев. В легких случаях болезнь не прогрессирует или прогрессирует медленно. В тяжелых случаях хронический гепатит ведет к постепенному фиброзу и циррозу печени.
Хронический гепатит – это заболевание, для которого характерны воспаление и некроз печеночной паренхимы, сохраняющиеся на протяжении шести и более месяцев. В легких случаях болезнь не прогрессирует или прогрессирует медленно. В тяжелых случаях хронический гепатит ведет к постепенному фиброзу и циррозу печени.
 Цитомегаловирус относится к семейству герпесвирусов. В зависимости от состояния иммунной системы человека заражение цитомегаловирусом может вызывать различные изменения: от бессимптомного течения и легкого мононуклеозоподобного синдрома до тяжелых системных инфекций с поражением легких, печени, почек и других органов.
Цитомегаловирус относится к семейству герпесвирусов. В зависимости от состояния иммунной системы человека заражение цитомегаловирусом может вызывать различные изменения: от бессимптомного течения и легкого мононуклеозоподобного синдрома до тяжелых системных инфекций с поражением легких, печени, почек и других органов.
 Всемирная организация здравоохранения /ВОЗ/ распространила справочные материалы по вопросам, возникающим в связи с распространением нового высокопатогенного вируса гриппа А/H1N1, называемого также свиным гриппом (однако начиная с 30 апреля, ВОЗ приняла решение отказаться от названия «свиной грипп» и использовать только официальное название "грипп А (H1N1)")
Всемирная организация здравоохранения /ВОЗ/ распространила справочные материалы по вопросам, возникающим в связи с распространением нового высокопатогенного вируса гриппа А/H1N1, называемого также свиным гриппом (однако начиная с 30 апреля, ВОЗ приняла решение отказаться от названия «свиной грипп» и использовать только официальное название "грипп А (H1N1)")
 Чесотка – паразитарное кожное заболевание, характеризующееся интенсивным ночным зудом, расчесами и образованием на коже чесоточных ходов. Чесотку вызывает клещ Sarcoptes scabiei, называемый в народе чесоточным зуднем. Самопроизвольно чесотка не проходит. Однако, чтобы излечить больного чесоткой, достаточно уничтожить клеща и его яйца, что легко достигается применением местных средств.
Чесотка – паразитарное кожное заболевание, характеризующееся интенсивным ночным зудом, расчесами и образованием на коже чесоточных ходов. Чесотку вызывает клещ Sarcoptes scabiei, называемый в народе чесоточным зуднем. Самопроизвольно чесотка не проходит. Однако, чтобы излечить больного чесоткой, достаточно уничтожить клеща и его яйца, что легко достигается применением местных средств.
 Чума представляет собой природно-очаговую острую инфекционную болезнь. Характеризуется лихорадкой, тяжелой интоксикацией, поражением лимфатических узлов, кожи и легких. Является особо опасной инфекцией!
Чума представляет собой природно-очаговую острую инфекционную болезнь. Характеризуется лихорадкой, тяжелой интоксикацией, поражением лимфатических узлов, кожи и легких. Является особо опасной инфекцией!
 Шигеллез или дизентерия представляют собой острое инфекционное заболевание, протекающее с общей интоксикацией и синдром поражения пищеварительной системы.
Шигеллез или дизентерия представляют собой острое инфекционное заболевание, протекающее с общей интоксикацией и синдром поражения пищеварительной системы.







